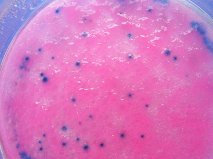
dry plate

Detección inmediata de Coagulasa de Staphylococcus aureus sin necesidad de plasma de conejo, por aglutinación a simple vista
coagulasa
Prueba rápida en látex para la identificación de Staphylococcus aureus (coagulasa y/o Proteina-A positivos), sean o no Meticilin resistentes, a partir de colonias sospechosas procedentes de medios generales e incluso de Baird Parker.
Numerosas especies de Staphylococcus resultan inocuas como comensales en la piel y las mucosas humanas.
Sin embargo, algunas de ellas son responsables de infecciones pyogénicas.
Staphylococcus aureus, en particular, puede causar lesiones supurantes superficiales, envenenamientos alimentarios y shock tóxico.
Su enterotoxina termorresistente provoca numerosas toxiinfecciones alimentarias en alimentos donde incluso el microorganismo ha muerto por procesado térmico, pero no así la actividad de la toxina que dejó previamente.
La coagulasa está envuelta en dos factores:
1- “clumping factor”, asociado a las células, que reacciona con el fibrinógeno;
2- Coagulasa libre extracelular y proteína A, también afín con las IgG.
MICROKIT-STAPH
está diseñado para reaccionar con todas las cepas capaces de aglutinar el fibrinógeno y la IgG, sea mediante “clumping factor”, proteína A o ambos.
El 99% de los Staphylococcus aureus aislados producen cantidades detectables de proteína A mientras las demás especies sólo raramente lo hacen, lo que convierte a esta característica en una prueba de identificación.
Staphylococcus aureus produce, además, una coagulasa característica (clumping factor) cuya actividad es base de dos pruebas diagnósticas tradicionales:
Los test de coagulasa en tubo y en porta.
Estos tests clásicos son, a menudo, lentos, difíciles de interpretar y sufren numerosos falsos positivos a causa de factores inespecíficos presentes en el plasma.
Otros tests de diagnóstico se basan en la hemaglutinación de la proteina A y en la capacidad de Staphylococcus aureus coagulasa positivos para digerir DNA.
Estas técnicas requieren prolongadas incubaciones de 18-24 horas.
Para reducir todas estas desventajas en la identificación de Staphylococcus aureus se han desarrollado los kits de aglutinación en porta que detectan la coagulasa y la proteina A, gracias al ligamiento de fibrinógeno e IgG a partículas de látex.
Al mezclar la colonia de Staphylococcus aureus, suspendida en salina, con el látex, se presenta una inmediata aglutinación de todas las partículas de látex, en grandes grumos, visibles sin necesidad de lupa, que aparecen sobre un fondo transparente.
Para más información sobre nuestros medios de cultivo y kits, no dude en ponerse en contacto con nosotros a través de nuestro correo electrónico microkit@microkit.es o por teléfono en el nº 91-897 46 16.
https://www.microkit.es/fichas/STAPH-COAGULASA-M-IDENT-LATEX.pdf
https://www.microkit.es/monograficos/1-Estafilococo-dorado-monograf–a.pdf
No se pierda el video de su modo de empleo: